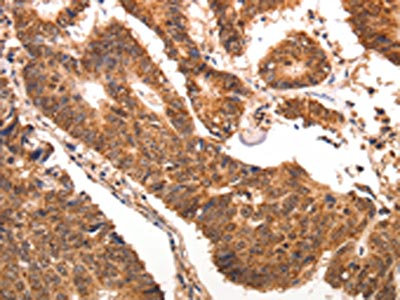

CCL17 Antibody
-
中文名稱(chēng):CCL17兔多克隆抗體
-
貨號(hào):CSB-PA113746
-
規(guī)格:¥1100
-
圖片:
-
The image is immunohistochemistry of paraffin-embedded human colon cancer tissue using CSB-PA113746(CCL17 Antibody) at dilution 1/70. (Original magnification: ×200)
-
The image is immunohistochemistry of paraffin-embedded human gastric cancer tissue using CSB-PA113746(CCL17 Antibody) at dilution 1/70. (Original magnification: ×200)
-
Gel: 15%SDS-PAGE, Lysate: 40 μg, Lane 1-3: Mouse lung tissue, Mouse thymus tissue, human fetal muscle tissue, Primary antibody: CSB-PA113746(CCL17 Antibody) at dilution 1/1300, Secondary antibody: Goat anti rabbit IgG at 1/8000 dilution, Exposure time: 45 seconds
-
-
其他:
產(chǎn)品詳情
-
Uniprot No.:
-
基因名:
-
別名:A-152E5.3 antibody; A152E53 antibody; ABCD 2 antibody; ABCD2 antibody; C-C motif chemokine 17 antibody; CC chemokine TARC antibody; CCL17 antibody; CCL17_HUMAN antibody; Chemokine CC Motif Ligand 17 antibody; MGC138271 antibody; MGC138273 antibody; SCYA17 antibody; Small Inducible Cytokine A17 antibody; Small Inducible Cytokine A17 Precursor antibody; Small Inducible Cytokine Subfamily A (Cys Cys) antibody; Small Inducible Cytokine Subfamily A (Cys Cys) Member 17 antibody; Small-inducible cytokine A17 antibody; T Cell Directed CC Chemokine antibody; Thymus and activation regulated chemokine antibody; Thymus and activation-regulated chemokine antibody
-
宿主:Rabbit
-
反應(yīng)種屬:Human,Mouse
-
免疫原:Synthetic peptide of Human CCL17
-
免疫原種屬:Homo sapiens (Human)
-
標(biāo)記方式:Non-conjugated
-
抗體亞型:IgG
-
純化方式:Antigen affinity purification
-
濃度:It differs from different batches. Please contact us to confirm it.
-
保存緩沖液:-20°C, pH7.4 PBS, 0.05% NaN3, 40% Glycerol
-
產(chǎn)品提供形式:Liquid
-
應(yīng)用范圍:ELISA,WB,IHC
-
推薦稀釋比:
Application Recommended Dilution ELISA 1:2000-1:5000 WB 1:500-1:2000 IHC 1:100-1:300 -
Protocols:
-
儲(chǔ)存條件:Upon receipt, store at -20°C or -80°C. Avoid repeated freeze.
-
貨期:Basically, we can dispatch the products out in 1-3 working days after receiving your orders. Delivery time maybe differs from different purchasing way or location, please kindly consult your local distributors for specific delivery time.
-
用途:For Research Use Only. Not for use in diagnostic or therapeutic procedures.
相關(guān)產(chǎn)品
靶點(diǎn)詳情
-
功能:Chemotactic factor for T-lymphocytes but not monocytes or granulocytes. May play a role in T-cell development in thymus and in trafficking and activation of mature T-cells. Binds to CCR4.
-
基因功能參考文獻(xiàn):
- The frequency of the CC genotype in the TARC rs223828 SNP was higher in patients with intractable Graves disease than in patients with Graves disease in remission. PMID: 29848886
- The expression of CCL17 was decreased in nasal polyp (NP) epithelium compared to the epithelium of normal ethmoid sinus, whereas the expression of CCL22 was not decreased. E-cadherin was differentially distributed between the epithelium of normal ethmoid sinus and NP epithelium. EGFR was also decreased in NPs. PMID: 29746583
- TARC serum levels were elevated in 78% of sarcoidosis patients and correlated with disease severity. PMID: 29598931
- Serum TARC level may be a potent marker reflecting better response to IL-17A inhibitors for psoriasis treatment. PMID: 29655215
- This review presents key clinical studies of Multiple sclerosis together with experimental studies in animals that have demonstrated functional roles of CCR4, CCL17, and CCL22 in experimental autoimmune encephalomyelitis pathogenesis. [review] PMID: 29099057
- Taken together, our data showed a likely positive feedback mechanism of enhanced IL-6 production in ectopic milieu. The high levels of IL-6 in the peritoneal cavity stimulate the expression of CCL17 in endometrial stromal cells by activating JNK signal pathway, and then, CCL17 further induces CCR4 expression on macrophages, which eventually leads to an increase in IL-6 production via NF-kappaB activation. PMID: 28240436
- Data suggest that high levels of CCL17 and CCL22 in endometrium in women with endometriosis promote (1) recruitment of Tregs, (2) immunosuppression of Tregs, and (3) angiogenesis in endometrium. (Tregs = regulatory T cells) PMID: 28383711
- Serum TARC levels correlate well with indicators of systemic inflammation and of disease severity among patients with a drug eruption except SJS/TEN. Serum TARC may be a prognostic biomarker of severity of inflammation in drug eruptions. PMID: 28648978
- TARC production in HaCaT keratinocytes through the interaction between IL-22 and IL-22Ralpha facilitates T-cell migration in atopic dermatitis caused by house dust mites. PMID: 26914146
- TARC is a candidate biomarker for PTSD only in males. PMID: 28170001
- High CCL17 expression is associated with colon cancer cell migration. PMID: 28146427
- GM-CSF can mediate inflammation and pain by regulating IRF4-induced CCL17 production PMID: 27525438
- Based on the ADEPT study data set, we report that airway mucosal expression of CCL26 was a robust discriminator of type 2 inflammation from healthy nonatopic subjects. Furthermore, airway mucosal CCL26 expression was best identified by using a panel of clinical biomarkers, including Feno values, bEOS counts, and expression of 2 novel markers, sCCL17 and sCCL26 PMID: 28089872
- Low CCL17 expression is a potential independent adverse prognostic biomarker for recurrence and survival of patients with clear cell renal cell carcinoma after nephrectomy. PMID: 28178948
- IP-10 serum increase or TARC/IP-10 ratio decrease along with abnormal hepatic enzymatic alteration could signify early rejection of the transplanted liver. PMID: 28245475
- elevated pre-treatment levels of sGal-1, sCD163, sCD30 and TARC can be found in patients with classic Hodgkin lymphoma. However, only plasma TARC accurately reflects disease activity and correlates with clinical treatment response. PMID: 27610595
- levels elevated in rheumatoid arthritis synovial fluid, due to production by mononuclear cells, particularly CD1c classical dendritic cells PMID: 27250804
- Serum TARC levels are well correlated with blood eosinophil counts in patients with generalized drug eruptions, indicating that Th2-type immune reactions underlie TARC production. Serum TARC measurements also have potent diagnostic value for DIHS, with high sensitivity and specificity. PMID: 27497618
- Data suggest that Th1 (IFN-gamma-inducible protein-10 IP-10/CXCL10) and Th2 (thymus and activation regulated chemokine TARC/CCL17) and (macrophage derived chemokine MDC/CCL22) cooperatively play a role in the development of ankylosing spondylitis (AS). PMID: 26827189
- CCL17 positively regulates the tumorigenesis of hepatocellular carcinoma.Higher levels of intratumoral CCL17 expression are associated with poorer survival of hepatocellular carcinoma patients. PMID: 26781124
- CCL17 and CCL18 dermal expression is associated with leprosy polarity. PMID: 25412496
- The SNP rs223895 in TARC/CCL17 gene is associated with the susceptibility to Kawasaki disease. PMID: 26182268
- Serum CCL17 levels are associated with coronary artery disease and atherosclerosis severity independently of traditional cardiovascular risk factors. PMID: 25555269
- TARC was correlated with disease status and its monitoring may be able to predict PET positivity after alloSCT, thus potentially allowing an early immune manipulation. PMID: 25240818
- Serum levels of CCL17 were positively correlated with coronary artery disease. PMID: 25062565
- increased expression in the thymus of myasthenia gravis patients PMID: 24397961
- TARC and interleukin-31 may be biomarkers for adult atopic dermatitis PMID: 24984931
- Serum TARC is a promising biomarker for remission and can be used for accurately monitoring proactive treatment for long-term control. [revew] PMID: 24628072
- disease activity and response biomarker in alopecia areata PMID: 24102731
- High CXCL10 levels were detected in acutely infected children regardless of virus pathogen, whereas increased CCL17 production was RSV-specific PMID: 25013801
- Higher serum concentrations of CCL17 at baseline may be predictive of acute exacerbations in patients with chronic hypersensitivity pneumonitis PMID: 23705860
- might be potential marker of non-eosinophilic oesophagitis gastrointestinal food allergies PMID: 24698291
- Serum TARC may represent a suitable biomarker for monitoring of atopic dermatitis severity in daily practice. PMID: 25199679
- Although TARC and I-TAC may not directly regulate pruritus in atopic dermatitis patients, these chemokines are very sensitive disease markers of AD. PMID: 24104601
- we found that TARC is an easily measured biomarker that is associated with faster TTR, longer PFS, and possibly longer OS in a population of patients with HL who were treated with panobinostat. PMID: 23822537
- The serum TARC level is a very sensitive biomarker for monitoring the severity and treatment response in AD PMID: 25268342
- CCL17 is an antimicrobial protein with bacteriocidal activity against E. coli and S. aureus. PMID: 12949249
- An association between TARC/CCL17 polymorphisms, susceptibility of Kawasaki disease, and intravenous immunoglobulin responses in Kawasaki disease patients. PMID: 23942559
- Migration assays were performed to evaluate CCL17-induced colon cancer cell (HT-29) chemotaxis and RhoA protein levels were quantified. PMID: 24582560
- Ginseng inhibited TARC expression via blockade of NF-kappaB activation in HaCaT cells. PMID: 23454147
- CCL17-induced, CCR4-dependent release of CGRP by human airway epithelial cells represents a novel inflammatory pathway in patients with asthma and allergic disease. PMID: 23731651
- These data reveal an elevated serum concentration of Th2-attracting chemokines CCL22 and CCL17 in opsoclonus-myoclonus syndrome. PMID: 23340773
- Autistic children had significantly higher serum levels of TARC than healthy controls PMID: 23782855
- Serum CD163 and TARC as disease response biomarkers in classical Hodgkin lymphoma. PMID: 23224400
- Data suggest an important role for serum CCL17 level as biomarker of drug resistance/remission induction in Hodgkin lymphoma in response to various combined neoplastic agent protocols. PMID: 23225085
- increased expression in macrophages from asthmatic patients PMID: 22981793
- Data show that PD-1, PD-L1, PD-L2, CCL17, and CCL22 mRNA was identified in papillomas. PMID: 22322668
- Serum concentrations of TARC and CTACK were significantly higher in AD (atopic dermatitis) children than in healthy controls, and correlated with severity of symptoms. PMID: 22017510
- Baseline plasma thymus and activation-regulated chemokine levels correlate with classical Hodgkin's lymphoma tumor burden and serial levels correlate with response to treatment in patients with classical Hodgkin's lymphoma. PMID: 22058214
- PI16-positive Treg showed enhanced in vitro migration towards the inflammatory chemokines CCL17 and CCL20, suggesting they can migrate to sites of inflammation PMID: 22533972
顯示更多
收起更多
-
亞細(xì)胞定位:Secreted.
-
蛋白家族:Intercrine beta (chemokine CC) family
-
組織特異性:Expressed at high levels in thymus and at low levels in the lung, colon and small intestine.
-
數(shù)據(jù)庫(kù)鏈接:
Most popular with customers
-
-
YWHAB Recombinant Monoclonal Antibody
Applications: ELISA, WB, IHC, IF, FC
Species Reactivity: Human, Mouse, Rat
-
Phospho-YAP1 (S127) Recombinant Monoclonal Antibody
Applications: ELISA, WB, IHC
Species Reactivity: Human
-
-
-
-
-